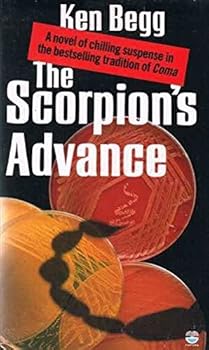
Paperback The Scorpion's Advance Book

The Scorpion's Advance
Select Format
Select Condition 
Book Overview
No Synopsis Available.
Format:Paperback
Language:English
ISBN:B002IEVOWE
ISBN13:9780006173472
Release Date:January 1986
Publisher:HarperCollins Publishers Canada, Limited
Length:256 Pages
Customer Reviews
0 rating